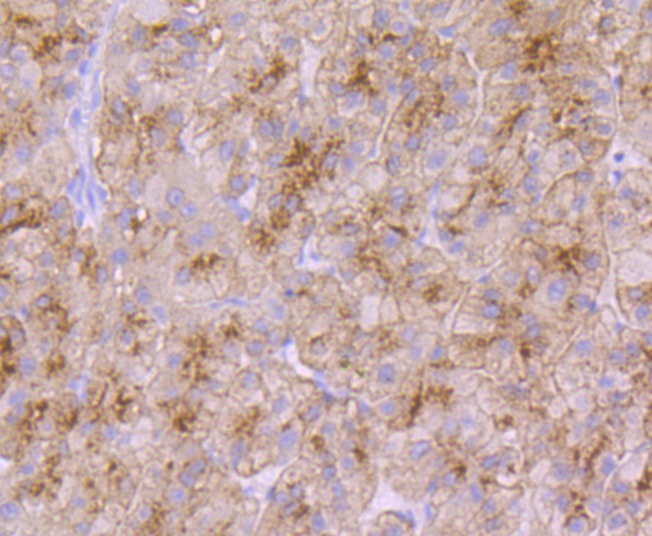

购物车
 您的购物车当前为空
您的购物车当前为空
Anti-Transferrin R2 Antibody (5U818) 是一种 Rabbit 抗体,靶向 Transferrin R2。Anti-Transferrin R2 Antibody (5U818) 可用于 IHC,WB。
别名 Trfr2, Transferrin receptor protein 2, TfR2
Anti-Transferrin R2 Antibody (5U818) 是一种 Rabbit 抗体,靶向 Transferrin R2。Anti-Transferrin R2 Antibody (5U818) 可用于 IHC,WB。
| 规格 | 价格 | 库存 | 数量 |
|---|---|---|---|
| 50 μL | ¥ 1,495 | 5日内发货 | |
| 100 μL | ¥ 2,495 | 5日内发货 |
TargetMol的所有产品仅用作科学研究或药证申报,不能被用于人体,我们不向个人提供产品和服务。请您遵守承诺用途,不得违反法律法规规定用于任何其他用途。
| 产品描述 | Anti-Transferrin R2 Antibody (5U818) is a Rabbit antibody targeting Transferrin R2. Anti-Transferrin R2 Antibody (5U818) can be used in IHC,WB. |
| 别名 | Trfr2, Transferrin receptor protein 2, TfR2 |
| Ig Type | IgG |
| 克隆号 | 5U818 |
| 反应种属 | Human |
| 验证活性 | 1. Western blot analysis of Transferrin Receptor 2 on HepG2 cell using anti-Transferrin Receptor 2 antibody at 1/1,000 dilution. 2. Immunohistochemical analysis of paraffin-embedded human liver tissue using anti-Transferrin Receptor 2 antibody. Counter stained with hematoxylin. 3. Immunohistochemical analysis of paraffin-embedded human liver cancer tissue using anti-Transferrin Receptor 2 antibody. Counter stained with hematoxylin. |
| 应用 | IHCWB |
| 推荐剂量 | WB: 1:500-2000; IHC: 1:50-200 |
| 抗体种类 | Monoclonal |
| 宿主来源 | Rabbit |
| 构建方式 | Recombinant Antibody |
| 纯化方式 | ProA affinity purified |
| 性状 | Liquid |
| 缓冲液 | 1*TBS (pH7.4), 1%BSA, 40%Glycerol. Preservative: 0.05% Sodium Azide. |
| 研究背景 | Iron is a vital molecule for living organisms because it is involved in a wide variety of metabolic processes, such as oxygen transport, DNA synthesis and electron transport. Excessive iron uptake leads to tissue damage as a result of formation of free radicals. Iron uptake and storage is tightly regulated by the feedback system of iron responsive element-containing gene products and iron regulatory proteins that modulate the expression levels of the genes involved in iron metabolism. The transferrin receptor 2 (TFR2) mediates the uptake of transferrin-bound iron. It is involved in iron metabolism, hepatocyte function and erythrocyte differentiation, and is highly expressed as a protein in liver as well as in hepatocytes and erythroid precursors. The gene encoding human TRF2 maps to chromosome 7q22 and is expressed as an a isoform, which encodes a transmembrane protein, and a b isoform, which encodes a shorter, intracellular protein. Mutations in the TFR2 gene result in hereditary hemochromatosis type III (HFE3), an iron overloading disorder that results in clinical complications, including cirrhosis, cardiopathy, diabetes, endocrine dysfunctions, arthropathy and susceptibility to liver cancer. |
| 偶联 | Unconjugated |
| Uniprot ID |
| 分子量 | Theoretical: 89 kDa. |
| 储存方式 | Store at -20°C or -80°C for 12 months. Avoid repeated freeze-thaw cycles. |
| 运输方式 | Shipping with blue ice. |